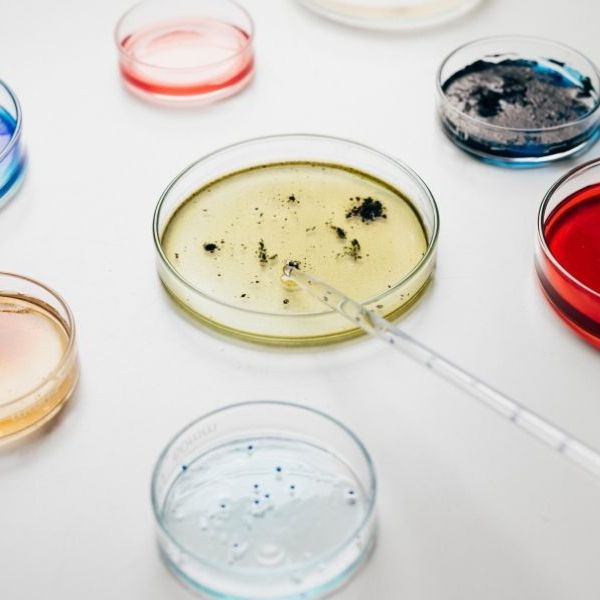
Hệ Thống Tưới

Danh Mục Sản Phẩm
Hena luôn kiên trì theo đuổi sự hoàn thiện và không ngừng đổi mới trong nghiên cứu, sản xuất và cung ứng. Chúng tôi mang đến những sản phẩm chất lượng, đồng hành cùng bà con trên hành trình xây dựng nền nông nghiệp xanh – sạch – bền vững.